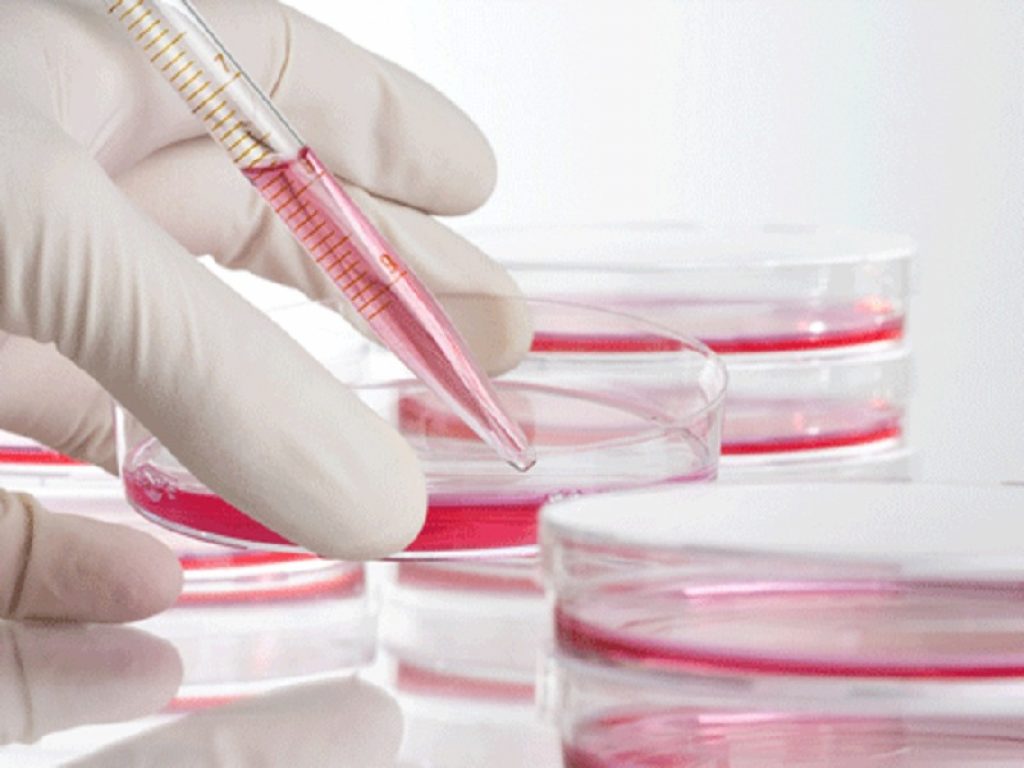
Linfoma non Hodgkin indolente recidivato:  copanlisib centra l'endpoint primario dello studio CHRONOS-3

Linfoma non Hodgkin indolente recidivato: copanlisib centra l’endpoint primario dello studio CHRONOS-3
Bayer ha annunciato oggi che lo studio di Fase III CHRONOS-3 che valuta copanlisib in combinazione con rituximab in pazienti affetti da linfoma non Hodgkin indolente (iNHL) (n=458) che hanno avuto una ricaduta dopo una o più linee precedenti di terapia contenente rituximab ha raggiunto il suo endpoint primario di sopravvivenza senza progressione (PFS).
Lo studio ha incluso prevalentemente pazienti con linfoma follicolare (FL) e linfoma della zona marginale, nonché pazienti con linfoma linfocitario di piccole dimensioni e linfomo/macroglobulinemia di Waldenström.
Nel 2017, sulla base dello studio di Fase II CHRONOS-1, copanlisib è stato approvato per il trattamento di pazienti adulti con FL recidivante che hanno ricevuto almeno due precedenti terapie sistemiche. L’approvazione accelerata è stata concessa per questa indicazione sulla base del tasso di risposta globale (ORR). L’approvazione continuativa per questa indicazione può dipendere dalla verifica e dalla descrizione del beneficio clinico in uno studio di conferma.
“Le forme indolenti di linfoma non Hodgkin sono un gruppo eterogeneo di tumori maligni caratterizzati da un modello cronico di remissioni e recidive. Per i pazienti iNHL con progressione della malattia che necessitano di un trattamento, ci sono poche opzioni di trattamento approvate”.
CHRONOS-3 è uno studio di Fase III randomizzato, in doppio cieco, controllato con placebo, con l’obiettivo di valutare se Aliqopa in combinazione con rituximab è superiore al placebo più rituximab nell’estendere la PFS in pazienti con iNHL recidiva dopo almeno un prodotto rituximab precedente. La sicurezza osservata nello studio è stata generalmente coerente con i dati pubblicati in precedenza sui singoli componenti della combinazione e non sono stati identificati nuovi segnali di sicurezza.
“Le forme indolenti di linfoma non Hodgkin sono un gruppo eterogeneo di tumori maligni caratterizzato da un modello cronico di remissioni e recidive. Per i pazienti iNHL con progressione della malattia che hanno bisogno di cure, ci sono poche opzioni terapeutiche approvate”, ha detto Scott Z. Fields, Senior Vice President e Head of Oncology Development della Bayer. “I risultati positivi di CHRONOS-3 dimostrano il potenziale beneficio clinico del copanlisib in combinazione con rituximab, per rispondere alle esigenze mediche insoddisfatte di questi pazienti”.
I risultati di CHRONOS-3 saranno presentati in un congresso scientifico. Bayer intende discutere i dati di CHRONOS-3 con le autorità sanitarie di tutto il mondo.
Copanlisib è un inibitore della fosfatidilinositolo-3-chinasi (PI3K) con attività predominante contro le isoforme alfa e delta le isoforme PI3K-alfa e PI3K-delta espresse nelle cellule B maligne. Il farmaco è approvato negli Stati Uniti secondo il percorso di approvazione accelerata per il trattamento di pazienti adulti con FL recidivante che hanno ricevuto almeno due precedenti terapie sistemiche.
Informazioni su CHRONOS-3
CHRONOS-3 è uno studio di Fase III randomizzato, in doppio cieco, controllato con placebo che valuta l’efficacia e la sicurezza di copanlisib in combinazione con rituximab contro placebo in combinazione con rituximab in pazienti con NHL indolente recidivato che hanno ricevuto almeno una o più linee di trattamento precedente contenente rituximab.
I sottotipi istologici inclusi nello studio sono stati il linfoma follicolare (FL), il piccolo linfoma linfocitico (SLL), il linfomo/macroglobulinemia linfoplasmocitoma valdenström (LPL/WM) e il linfoma della zona marginale (MZL). I pazienti devono avere avuto una ricaduta dopo l’ultima terapia contenente rituximab e devono avere avuto un intervallo libero da trattamento di ≥ 12 mesi dopo il completamento del trattamento contenente rituximab, oppure non sono disposti a ricevere la chemioterapia o per i quali la chemioterapia è controindicata a causa dell’età, delle comorbilità e/o della tossicità residua (NCT02367040). Lo studio ha arruolato 458 pazienti.